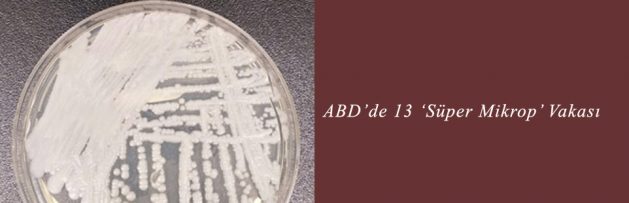
ABD’de 13 ‘Süper Mikrop’ Vakası

ABD’de 13 ‘Süper Mikrop’ Vakası
![]()
4 Kasım 2016
Federal sağlık yetkilileri, ABD’de Mayıs 2013 ve Ağustos 2016 arasında 13 antibiyotiğe dirençli Candida auris infeksiyonu bildirildiğini, bunların dördünde hastaların hayatını kaybettiğini açıkladı. Ancak ölümlerin infeksiyondan mı yoksa hastaların sağlık durumundan mı kaynaklandığının net olmadığı belirtildi.
Candida auris isimli mantar infeksiyonu tüm dünya için bir risk faktörü olarak görülüyor ve CDC tarafından ABD’de hastaneler ve sağlık merkezlerinde yaygınlaştığı bildiriliyor.
ABD’de bildirilen 13 vakanın yedisi CDC’nin 4 Kasım tarihli Morbidity and Mortality Weekly Report adlı yayınında aktarılıyor. Diğer altısıysa halen incelenmeye devam ediliyor.
Raporda bildirilen yedi vakada da hastaların durumlarının ciddi olduğu ve C. auris tanısı konduğunda ortalama 18 gün hastane yatışı bulunduğu bildiriliyor.
Aynı sağlık merkezinde tedavi edilen iki hastada suşların neredeyse birebir aynı olması mantarın merkezler içerisinde yayılabildiğini gösteriyor. Haziran ayında CDC, C. auris’in dünyada yayılımı hakkında klinik bir uyarı yayımlamıştı.
CDC, C. auris infeksiyonu laboratuvar testi olmadan kolaylıkla başka bir Candida infeksiyonuyla karışabildiği için tüm hasta örneklerinin gönderilmesini talep etmişti.
Haberin Tam Metni için [Tıklayınız]